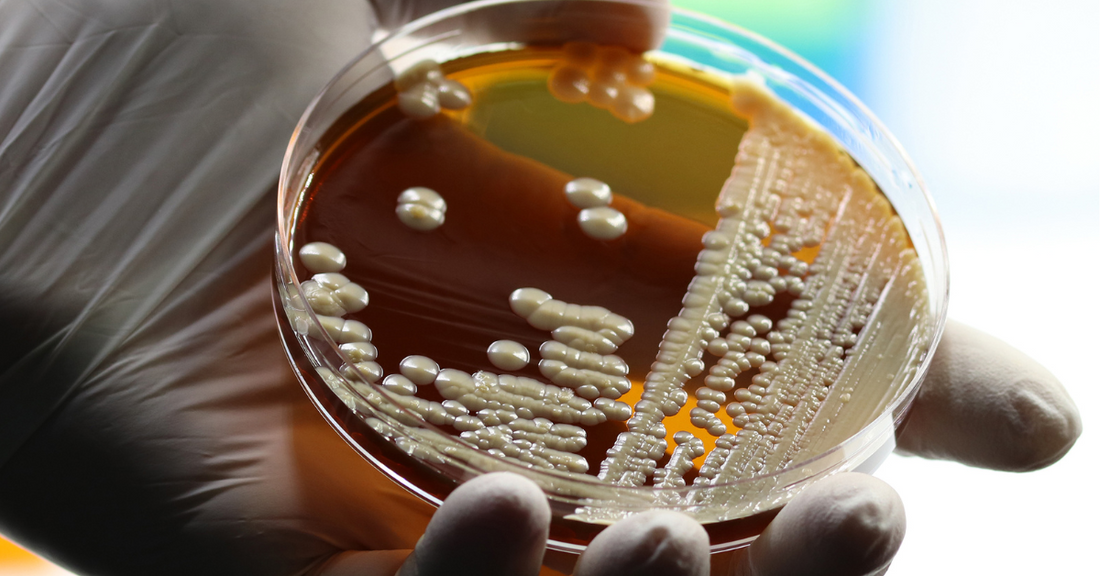

How to Tell If Your Probiotics Are Working: 7 Proven Signs for a Healthier Gut
Share
Β
Wondering if your probiotics are really working? Discover 7 proven signs from smoother digestion and reduced bloating to clearer skin, stronger immunity, and better mood. Learn what to expect, how long it usually takes, and why listening to your body is key to getting the most out of your probiotic supplement.
Introduction
Probiotics are live βgoodβ bacteria that support gut balance, digestion, immunity, and even mood. They also live in the mouth, skin, and urinary tract, where they help keep harmful microbes in check.
7 Signs Your Probiotics Are Working
-
More regular bowel movements
- Less straining; smoother consistency.
- Often noticeable within 2β4 weeks.
-
Less gas and bloating
- Reduced abdominal pressure after meals.
- Improved tolerance to fiber-rich foods.
-
Improved immune function
- Fewer colds or mild infections.
- Better overall resilience.
-
Clearer skin
- Fewer flare-ups (acne, rashes).
- Calmer, less reactive skin.
-
Better mood
- More stable energy and outlook.
- Less digestive-related anxiety.
-
Fewer food sensitivities
- Less discomfort after trigger foods.
- Improved tolerance over time.
-
Increased energy levels
- Better nutrient absorption.
- Less mid-day slump.
How Long Until Probiotics Work?
Most people notice changes within 2β4 weeks. Timing varies by strain, dose, diet, and baseline gut health. If you see no change after a month, consider a different formula.
Types of Probiotics and Benefits
Strain family | Common sources | Key benefits |
---|---|---|
Lactobacillus | Yogurt, fermented foods | Helps lactose digestion; may reduce diarrhea |
Bifidobacterium | Dairy products | Supports comfort in IBS (gas, bloating) |
How Probiotics Work
Three steps
- Survival: endure stomach acidity.
- Colonization: multiply and establish in the gut.
- Inhibition: outcompete harmful microbes.
Conclusion
Listen to your body: steadier digestion, less bloating, better energy, and calmer skin suggest your probiotics are on track. No changes after 4 weeks? Try another strain or speak with a clinician.
Next step: Choose a clinically backed formula and track your weekly symptoms to confirm results.
Β
The information provided in this article is for general informational purposes only. It is not intended as a substitute for professional medical advice, diagnosis, or treatment. Always seek the advice of your physician or another qualified healthcare provider with any questions you may have regarding a medical condition. Never disregard professional medical advice or delay in seeking it because of something you have read on this website. If you think you may have a medical emergency, call your doctor or emergency services immediately.